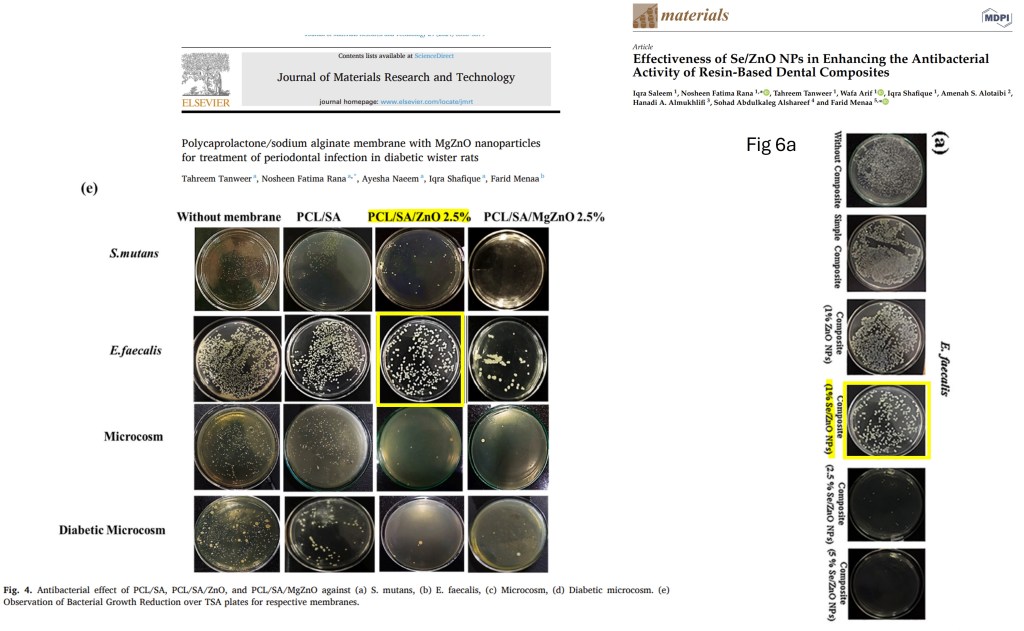

Mu Yang vs Elsevier, where one journal at a time will bite the dust.
This time, the focus is on bad corrections. In one episode, our superhero and her team hunt down a rogue editor who allowed papermill fraudsters to replace eleven figures in a correction.
Are you ready for this?
Are you hanging on the edge of your seat?

The Incorrigible Elsevier
By Mu Yang
Thanks to Elsevier, I suddenly started to doubt the consequences of my fervent sleuthing deeds. I had always believed that pointing out everything that should be pointed out —- be it simple errors or intentional fraud —- will help to paint “the big picture”, clean up the field, build trust, and improve scientific integrity. All those noble goals and aspirations.
Until I woke up seeing Elsevier’s giant middle finger in front of my face.
I had no idea, that by reporting a massive number of papers with “serious issues”, I have been unintentionally helping papermills to launder their “research papers” into the literature, thereby cementing what I was trying to rid off. I also had no idea, that what we think are the gatekeepers — publisher, journal editors-in-chief — are very often part of the problem, not the solution. It’s like when the police chief not only lets the criminals out from the back door, he also gives them new IDs.
Journal of Molecular Liquids vs One-Man Papermills
Mu Yang catches two crooks, Ayman Atta and S Muthu, who flooded one Elsevier journal (and several others) with ridiculous hand-drawn fraud. Whom to believe, the peer review, or your own eyes?
It started with a daunting task of tackling several papermills (that a whistleblower alerted me of). I am not sure if there is an official definition for papermill, but if someone at King Khalid University publishes over 140 papers in less than a year, something is fishy. Quickly realizing that I was in an unfamiliar territory of chemistry, physics, and materials science, I teamed up with subject-matter sleuths (Reese Richardson, Professor Valentin Rodionov, Dr. Furqan Shah, and Dr. Nikolay Tumanov). By summer 2024, we have reported hundreds of papers to various publishers. Notably, a staggering number (approximately 150) of flagged papers were published in Elsevier journals. And do you think Elsevier would be alarmed into taking serious actions?
Three short months later, the “Corrections” started to spring up (!) and up(!) and up(!), mocking our miniscule lingering trust and hope.
Journal of Energy Storage
This journal was already subject to For Better Science reporting, the previous editor, the German professor Dirk-Uwe Sauer, had to resign due to incessant sleuthing by Alexander Magazinov. An entire special issue was flagged with Expressions of Concern, its papers are being gradually retracted:
Maybe stop accepting submissions, Herr Prof Dr Sauer?
Who needs science if you can have a 75 paper strong special edition by Afrand and Karimi? A guest post by Alexander Magazinov.
The new Editor-in-chief Dr Luisa F. Cabeza, professor at University of Lleida in Spain, is passionate about climate change (as EU’s Climate Pact ambassador), she also has a themed issue of a MDPI journal dedicated to her. Also her own papers were flagged on PubPeer, for issues of self-plagiarism.
When reminded of the FOUR EDX graphs that look very much alike (especially the sections indicated by the pink boxes), and asked about what led to the editorial decision to “correct” Farid et al 2023 (right-most EDX, below), Prof Cabeza’s answer was curt:
“To make our previous decision, we made a throughout investigation of the case, and we came to the fact that we do not have enough evidence of papermill or other misconduct. If more evidence would be sent to us, we could reconsider our decision. We appreciate your concern“.
Thorough investigation?
Hafiz Muhammad Tahir Farid, Soumaya Gouadria, S.M. Al-Moayid , H. Algarni , Mohd Zahid Ansari, H. Elhosiny Ali Facile synthesis of CuCo2O4 spinel with rGO nanocomposite via hydrothermal approach for solid state supercapacitor application Journal of Energy Storage (2023) doi: 10.1016/j.est.2023.107394

As a card-carrying complete noob about chemistry, I am confident in my understanding that “noises” from different materials do not replicate. The blue and green traces in the original Fig 1a were almost pixel identical. This, from what I have learned, is not a mistake that can be made unintentionally.

Interestingly, the authors did not dispute what we flagged, but meekly apologized:
” the authors regret that the original version of the published article contained misleading labeling of Figs. 1 and 2. We really apologize for this mistake. Now both figures (Figs. 1 and 2) are labeled correctly in the corrigendum. These changes do not alter the experimental results or the conclusion presented in this research paper.”
Corrigendum 1 October 2024
Mislabeled? As shown below, the “corrected” Fig 2 differs from the original in peak shape, peak assignment, peak location, and noise level. Dr. Rodionov put it more straightforwardly “…the obviously manipulated Fig. 2 was replaced with new data without explanation.“

Thinking that the Editors-in-Chief may not have opened attachments in our previous emails, I pasted the side-by-side image of 2 out of 4 papers in the email text body, thinking that everyone would be able to see easily, that those are near-identical EDX with the peaks assigned to W in the Inorganic Chemistry Communications paper (Ejaz et al 2023) were assigned to Cu in the Journal of Energy Storage paper (Farid et al 2023, below). Sotiri Hadjikakou, professor at Aristotle University of Thessaloniki in Greece and the erudite Editor-in-Chief of Inorganic Chemistry Communications chimed in:
“.. it is not entirely clear whether the spectra are identical or if there are slight differences, which may have allowed the reviewers to proceed with the acceptance of the papers based on the data presented.“
Syeda Rabia Ejaz , H.I. Elsaeedy , M. Asif Iqbal , Hafiz Muhammad Tahir Farid Facile synthesis of silver doped WO3 nanocomposite with 2-D reduced graphene oxide to boost photocatalytic efficiency Inorganic Chemistry Communications (2023) doi: 10.1016/j.inoche.2023.111354

To this, Dr. Rodionov retorted:
- “W does not have a peak at ~7.9 keV. There is a single L3 peak at ~8.4 keV, but we won’t be “seeing double” in that region.
- Likewise, what is probably attributed to the W M4 at ~1.25 keV is in the wrong place and has wrong intensity.
- The Ag peak at ~3 keV is there, but it is not a characteristic double peak. The intensity of that peak is inconsistent with the claimed stoichiometry.
- The O and C peaks are in the wrong place, and their intensity is inconsistent with the claimed stoichiometry.
- The “ovoid” line shape and the “tilt” in one of the purported W peaks is unusual and rather unprecedented.”
And Dr. Hadjikakou went silent.
Sir Harry’s Full Withdraw
“First you are starting that this issue is fraud, which is a negative attitude. I always would like to give the other part the benefit of the doubt.” – Sir Prof. dr. Harry W.M. Steinbusch
Another paper that one of the four look-alike (“strangely round, almost parabolic” as described by Reese Richardson) EDX was found in, Donya et al2024 , also went through a sneaky correction and came out squeaky clean.
Hossam Donya, Salma Aman, Naseeb Ahmad, Hafiz Muhammad Tahir Farid, Taha Abdel Mohaymen Taha Development of SnCo2O4 spinel supported on the rGO nanosheet with the improved electrochemical performance of OER activity International Journal of Hydrogen Energy (2024) doi: 10.1016/j.ijhydene.2023.06.238

Hafiz Muhammad Tahir Farid (who has SEVENTY-SIX papers on PubPeer) wrote to “Dear Editor”:
“….Further investigation revealed that a mix-up of old and new files (unintentional) in a similar folder led to this error and wrong labelling in the EDX spectrum. This unintended mix-up of the files led us to this error in the current paper.” […] We have informed all the authors of this paper about this mix-up and have made a detailed investigation into the validity of the results, which confirms that the conclusion and scientific merit of the work remain unaffected”.
Request for Erratum 19 August 2024
The original and “corrected” EDX are almost entirely different, how’s that not affecting the conclusion and scientific merit is dubious.
As the astute François-Xavier Coudert pointed out on X, scale bars was changed from 200 nm to 500 nm without explanation.

Coudert then followed up on PubPeer:

The authors did not argue, but simple pointed out the fact that a corrigendum has been published, in effect laughing at sleuths’ effort to correct the actual wrong. This illustrates that Elsevier is not only loosening the criteria to publish, but also actively helping to cement misinformation into the literature.
My urge to contact the EIC subsided, when I learned about this journal in a 2021 article by LS: “It is run by a father and son team: the Turkey-born University of Miami emeritus professor T. Nejat Veziroglu is the founding editor, and the junior Emre A. Veziroglu, a quality assurance manager who never worked in academia and whose highest academic degree is MSc, acts as the Editor-in-Chief. “
Erdogan’s academic elites
Önder Metin had a rogue PhD student whom he trusted “to ensure their academic growth”. But “mistakes were made by mistake”, conclusions are never affected. Yet those who still complain, will pay dearly.
Back to the Editor-in-Chief of Journal of Energy Storage. A quick search on the journal’s website shows that Dr Cabeza has over 50 papers in that journal, over 10 in just 2024.
Another interesting J. Energy Storage paper that was “corrected” was Abdullah et al., 2022. Reese Richardson and I flagged broken lines and backtracking figures.
Muhammad Abdullah , Peter John, Sumaira Manzoor , Muhammad Ishfaq Ghouri , H.H. Hegazy , Adeel Hussain Chugtai , Salma Aman , Ahmed M. Shawky , Muhammad Naeem Ashiq, T.A. Taha Facile fabrication of CuO/Ag2Se nanosized composite via hydrothermal approach for the electrochemical energy conversion system Journal of Energy Storage (2022) doi: 10.1016/j.est.2022.105929

The authors explained:
“We have observed that in the spectrum of XRD, presented in Figs. 2 and 7d, there was an error while processing and graphing, leading to the deletion of a significant point that cause appearance of discontinuous spectrum. We apologize as this has been overlooked in the submission process, due to student error. We have now corrected the Figure and no baseline correction or smoothening operations applied.”
Corrigendum 20 October 2024
The corrected Fig 2 has some interesting bonus: the purple trace which was NOT flagged now had a new look which includes 4 new peaks!

We don’t know why.
Journal of Materials Research and Technology (JMR&T)
JMR & T issued a number of highly questionable corrections on papers that we reported. The Editor-in-Chief, the 78 year old Distinguished Professor at the University of California San Diego, Dr. Marc Andre Meyers, was considered a respectable scientist by some of us at some point. Disappointed, I now write this open letter to him:
Dear Dr. Meyers,
I am writing to express my deep concerns on the editorial decisions to publish Corrigenda on multiple papers in Journal of Materials Research and Technology.
The papers I am referring to are:
- Rabia Ramzan , Muhammad Tariq , Muhammad Naeem Ashiq , Hind Albalawi , Imtiaz Ahmad , M.H. Alhossainy , Syeda Rabia Ejaz , Rabia Yasmin Khosa , Hafiz Muhammad Tahir Farid , Hasan M. Khan , Tahani I. Al-Muhimeedh , Abeer A. AlObaid Effect of yttrium ion on electrical and magnetic properties of barium based spinel ferrites Journal of Materials Research and Technology (2021) doi: 10.1016/j.jmrt.2021.03.001 (Correction)
- Abdul Hakeem , Thamraa Alshahrani , Ghulam Muhammad , M.H. Alhossainy , A. Laref , Abdul Rauf Khan , Irshad Ali , Hafiz Muhammad Tahir Farid , T. Ghrib , Syeda Rabia Ejaz , Rabia Yasmin Khosa Magnetic, dielectric and structural properties of spinel ferrites synthesized by sol-gel method Journal of Materials Research and Technology (2021) doi: 10.1016/j.jmrt.2020.12.064 (Correction)
- M.A. Almessiere, Y. Slimani , A.V. Trukhanov , A. Demir Korkmaz , S. Guner , S. Akhtar , Sagar E. Shirsath , A. Baykal , I. Ercan Effect of Nd-Y co-substitution on structural, magnetic, optical and microwave properties of NiCuZn nanospinel ferrites Journal of Materials Research and Technology (2020) doi: 10.1016/j.jmrt.2020.08.027 (Correction)
Ramza et al 2021 was flagged because it is one of eight papers by Farid that used just six types of traces (in different color and order) to indicate a wide range of materials. I classified the traces A-F. In the summary below, the most characteristic segments of the trace motifs are shown, to let people see how the traces were re-used. Ramza et al 2021 JMR & T is the second paper to the left.

A close-up look at the Ramza paper and another Farid paper reveals how the traces were re-used. Double-sided arrows point to traces that are re-used between papers.

The editorial decision to allow a correction to be published unfortunately reflects a lack of careful review of the evidence provided by us, and the contextual evidence on PubPeer.
An even more concerning correction was published for Hakeem et al 2021. The paper was flagged because its content was strikingly similar to another paper by Hakeem et al. Here are two examples:


Abdul Hakeem , Thamraa Alshahrani , Hafiz Muhammad Tahir Farid , Abdul Rauf Khan , M. H. Alhossainy , A. Laref , Irshad Ali Manganese-based spinel ferrites for microwave absorption Journal of Materials Science: Materials in Electronics (2021) doi: 10.1007/s10854-020-05022-x
I flagged a total of 5 figures as near-identical between the two papers. To my surprise, a Corrigendum was published and the only explanation given there was:
“The authors regret this unintended mix-up of the files led us to this error in the current paper. We sincerely apologize for this oversight and any confusion it may have caused. We really apologize for this mistake.”.
Corrigendum September 2024
I find it unbelievable that you deemed the explanation from the authors reasonable, and published ELEVEN new figures and 1 new table in a “Corrigendum”. As someone with zero training in material sciences, I nevertheless want to point out that the corrected data often bear little resemblance to the original. For example, the y axis scale in the corrected Fig 4 is about 3x that of the original Fig 4. I can’t imagine such a change would have no impact on the qualitative outcomes of the paper.

There are more examples. With all due respect, “unintended mix-up of the files” is as valid as “my dog ate my homework”.
We further discovered that Fig 2 in the JMR & T paper (before correction) is identical to Fig 1b in Ahmad et a 2023.

Imtiaz Ahmad , Muhammad Zeshan , Meznah M. Alanazi , Shaimaa A.M. Abdelmohsen , Hafiz Muhammad Tahir Farid Study of CoCe0.05Fe1.95O4-polypyrrole composite for efficient electromagnetic interference shielding Current Applied Physics (2023) doi: 10.1016/j.cap.2023.05.001
The third correction, for Almessiere et al., 2020, is similar poorly justified. As flagged, Fig 2 in the Almessiere JMR & T paper contains within-paper duplications (indicated by yellow and blue boxes) and between-paper duplication (pink boxes). In the Corrigendum, the authors noted
“The authors regret to inform that there is an error in Fig. 2 in the original published version of the article (https://doi.org/10.1016/j.jmrt .2020.08.027) as some SEM images were unintentionally duplicated during the process of copying and pasting from multiple SEM files, the arrangement of different images into the PowerPoint, and then the selection of images to be presented in the paper. Fortunately, the authors confirm that no any of the other results were affected by this unintentional error. The corrected version of Fig. 2 is attached. The authors would like to apologise for any inconvenience caused by this unintentional error.”.
Corrigendum September 2024

Which one is the “AN ERROR”, if four out of six images were changed out?
Dr. Meyers did not respond to an earlier version of this letter or any other emails from me.
However, Dr. Meyers allegedly replied nonchalantly to another concerned reader’s inquiry regarding the “correction” that involved swapping out 11 out of 14 figures:
“Indeed, this is a gross lack of attention by the authors. But life goes on, as science globalizes, Marc‘”.
LS contacted Meyers about this message and its racist implication about non-white scientists, but he didn’t reply.
Everything can corrected!
An unresponsive Editor-in-Chief is usually the reason for me look more deeply into a journal. Since I am particularly interested in papers that have been corrected, I searched for “corrigendum” in JMR & T. It turned out to be quite a treasure hunt.
First, we have Tanweer et al 2024, a study on periodontal infection in rats. Except that the authors seemed confused on what rats they used. The “Wister rats” in the original title was changed to “wistaar rats” in the corrigendum.
Tahreem Tanweer , Nosheen Fatima Rana , Ayesha Naeem , Iqra Shafique , Farid Menaa Polycaprolactone/sodium alginate membrane with MgZnO nanoparticles for treatment of periodontal infection in diabetic wistaar rats Journal of Materials Research and Technology (2024) doi: 10.1016/j.jmrt.2024.02.005

A further look revealed something beyond a silly typo — a same image was used to indicate bacteria treated with different substances, PCL/SA/ZnO 2.5% in the Tanweer paper and 1% Se/ZnO NPs in another paper by the group (Saleem et al., 2022).
Iqra Saleem , Nosheen Fatima Rana , Tahreem Tanweer , Wafa Arif , Iqra Shafique , Amenah S. Alotaibi , Hanadi A. Almukhlifi , Sohad Abdulkaleg Alshareef , Farid Menaa Effectiveness of Se/ZnO NPs in Enhancing the Antibacterial Activity of Resin-Based Dental Composites Materials (2022) doi: 10.3390/ma15217827
Or take Prakash et al 2020, where the correction of which added a citation (a paper from the authors) to a figure legend:
Chander Prakash , Sunpreet Singh , Animesh Basak , Grzegorz Królczyk , Alokesh Pramanik , Luciano Lamberti , Catalin I. Pruncu Processing of Ti50Nb50−xHAx composites by rapid microwave sintering technique for biomedical applications Journal of Materials Research and Technology (2020) doi: 10.1016/j.jmrt.2019.10.051

You may have noticed among the authors Grzegorz Królczyk. If you have not, read about him and his coauthors below and in August 2024 Shorts on this site.
Polish science eaten by Papermill Krolczyk
“Prof. Grzegorz Królczyk, Vice-Rector for Science and Development of the Opole University of Technology, was elected President of the Council for Innovation in Higher Education and Science.”
Also, it didn’t escape my eyes that the three traces in Fig 8 have nearly the same noise.

In this correction in Journal of Alloys and Compounds, the “corrected” Acknowledgment now only lists support from King Khalid University (KKU), dropping the text on the funding of the senior author Alex Trukhanov (who has 3 affiliations, two in Russia and one in Belarus). Curiously, only the second author alone is from KKU. Is KKU a philanthropic agency that supports international collaborations?
Dalal A. Alshammari , Inas A. Ahmed , Karam Jabbour , Zeinhom M. El-Bahy , Sergei Trukhanov , M.I. Sayyed , Daria Tishkevich , Alex Trukhanov Development of Te-CeO2/NF nanofilm with ultralow overpotential for robust oxygen evolution reaction Journal of Alloys and Compounds (2023) doi: 10.1016/j.jallcom.2023.171359

Or this this paper (Hussain et al 2024) that I flagged in the aforementioned International Journal of Hydrogen Energy. It was laundered in September 2024 with a simple excuse that “labelling in Fig. 2 (c) was wrong“.
Mukhtiar Hussain, Meznah M. Alanazi , Saeed D. Alahmari , Muhammad Abdullah , Khursheed Ahmad , A.M.A. Henaish , Gul Khan , Abdullah G. Al-Sehemi Effect of Sm dopant on electrocatalytic activity of AgNbO3 perovskite fabricated by sonication method for Oxygen Evaluation Reaction (OER) International Journal of Hydrogen Energy (2024) doi: 10.1016/j.ijhydene.2024.05.122

Readers can see that the entire EDX was swapped out.
Or this Slimani et al 2020 paper in Results in Physics,
Y. Slimani , B. Unal , M.A. Almessiere , A. Demir Korkmaz , Sagar E. Shirsath , Ghulam Yasin , A.V. Trukhanov , A. Baykal Investigation of structural and physical properties of Eu3+ ions substituted Ni0.4Cu0.2Zn0.4Fe2O4 spinel ferrite nanoparticles prepared via sonochemical approach Results in Physics (2020) doi: 10.1016/j.rinp.2020.103061

In an attempt to correct three (out of six!) overlapping images, the authors swapped out the lower right image in the Corrigendum as well, without any explanation.
Or in this paper in Ceramics International by HMT Farid, Fig 4c was changed without an explanation.
Tehreem Zahra , Meznah M. Alanazi , Shaimaa A.M. Abdelmohsen , Saeed D. Alahmari , Muhammad Abdullah , Salma Aman, A. Dahshan , A.M.A. Henaish , Zubair Ahmad , Hafiz Muhammad Tahir Farid Fabrication of MnAl2O4/g-CN nanohybrid as an advantageous electrode for supercapacitor applications Ceramics International (2024) doi: 10.1016/j.ceramint.2024.01.359

The bottom line is, kids, everything can be corrected (whether they should be or not). The only thing you need to say is is “That was a mistake, and I am very sorry!”, like how you learned in the second grade. Hand in a new version labeled “CORRECT” to the editor. That’s it. No, nobody will ask you how the mistake was made, who made the mistake, how do you know it was a mistake and not fraud, how do you verify that the new version is actually correct, how do you know the change does not affect the results or the conclusion etc. etc. etc.
Elsevier chooses Papermills and Patriarchy, Chief Editor resigns
“Among these candidates that you “vetted” were people with no expertise in the field (either 0 or 1 publication), people with longer PubPeer profiles and more retractions than most people have articles on their CVs, and people whose names appear as authors on sold paper sites. ” – Jillian Goldfarb
I predict the 2025 sleuthing trend to be “double — reporting”, that is, initial reporting followed by re-reporting of many ill-justified corrigenda. Because many of Elsevier journal Editors-in-Chief are giant toddlers who need to be spoon fed, but will spit out anyway, and you have to re-feed. When not watched, they would happily ingest “forever chemicals” to stay developmentally delayed.

Donate!
If you are interested to support my work, you can leave here a small tip of $5. Or several of small tips, just increase the amount as you like (2x=€10; 5x=€25). Your generous patronage of my journalism will be most appreciated!
€5.00


As a student who has just started scientific research work.
I am aware that if there are mistakes in my work, I must admit them and bear the consequences of those mistakes.
I believe that only in this way can one maintain a good inner self and make one’s character honest and upright.
For these papers, readers need an explanation from the author, publisher, and editorial department.
Thank you Dr. Leonid Schneider for sharing, and thank you to the scientific detectives for their hard work.
You are all morally upright people.
Also, Dr. Mu Yang is so cool, even cooler than Sherlock Holmes.
LikeLiked by 1 person
Thank you Mu Yang. She has made an outstanding effort and created a wonderful article. The frustrating part is very frustrating indeed. You catch the scammers and as Mu Yang said, the police chief send them out the back door with a new ID. It’s absolutely frustrating.
Once again it becomes clear that Elsevier is the real problem. Not just one publisher, but the biggest publisher. It also owns Scopus. So it’s a scientific data collector, a scientific data evaluator, a scientific data disseminator, and a scientific data and performance indexer. It has created a complete monopoly. With the comfort of this, they tolerate papermill activities that make them money by making problematic names editors of journals.
I wanted to take a brief look at Cabeza, but she has a publication profile that is too long and problematic for a brief look. She has 35 articles in the year 2024 alone. What she has done in her papers flagged on Pubpeer is not only nauseating, but it seems that they are a small percentage of the tip of the iceberg.
If they make such a profile editor-in-chief, of course that journal can host nothing but trash. What I am curious about now is how many Horizon projects Cabeza has been involved in with this problematic profile and ethics and who her partners are. Because what I have learned so far is that the biggest source of funding for papermillers is public funding.
It’s shame, so much shame. I think to stop these names the first thing to do is to stop Elsevier’s shameful policy!
LikeLike
Because many of Elsevier journal Editors-in-Chief are giant toddlers who need to be spoon fed, but will spit out anyway, and you have to re-feed. When not watched, they would happily ingest “forever chemicals” to stay developmentally delayed.:-)))I noticed that Cabeza was (1) Spanish and (2) into the energy/solar/… business. Which may me think of A. Inés Fernández, who has a small role in this ForBetterScience Chamkha/nanofluid story. She and her co-authors managed to write a ‘review’ that hoisted every nanofluid fraud on a big pedestal. And they then managed to publish it in a predatory journal that has the biggest nanofluid fraud as EiC.
Cabeza and Fernández happen to have published 90 papers together.
LikeLike
Dr Mu Yang you did an excellent job, keep up the good work!
LikeLiked by 2 people
I fully agree – correctios are an invaluable source of information. Changes of authors, corrections of authors’ names, changes of affiliations. Smells of papermills? And all this with the permission from the editors.
LikeLiked by 1 person